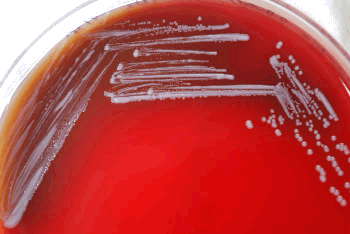

Dog Blood Pregnancy Test
"Blood Tests Personalabs Groupon, How Long Are Dogs Pregnant And What Happens During , veterinary medicine surgery singapore toa payoh vets , Blood chemistry Dogs and Cats , What to Do When Your Dog Bites Children , Why Does My Dog Poop In the House How Can I Stop It , Blood chemistry Dogs and Cats , Brucellosis Canine Mar Vista Animal Medical Center, Ivomec Pour On Generic Revival Animal Health, Azithromycin Suspension Revival Animal Health, ANTI CALLUS CREAM Scholl Paramarket com, Cavapoo Dog Breed Information Buying Advice Photos and , Cavapoo Dog Breed Information Buying Advice Photos and , , : SketchUp, : SketchUp, here it comes are you ready"
Best Post
Popular Post
✔ A dog can live how many years
✔ Dog house rescue
✔ B joo topp dogg age
✔ Dog hit by car swollen leg
✔ Dog man world book day
✔ Dog trainer tv show
✔ Dog detectives tv show quest red
✔ Dog and newborn baby
✔ Dog man online
✔ Dog lick cellulitis
✔ Dog treadmill for sale in pakistan
✔ Animal v animal fights
✔ Dog fashion disco looking for love lyrics
✔ Dog wakes baby up